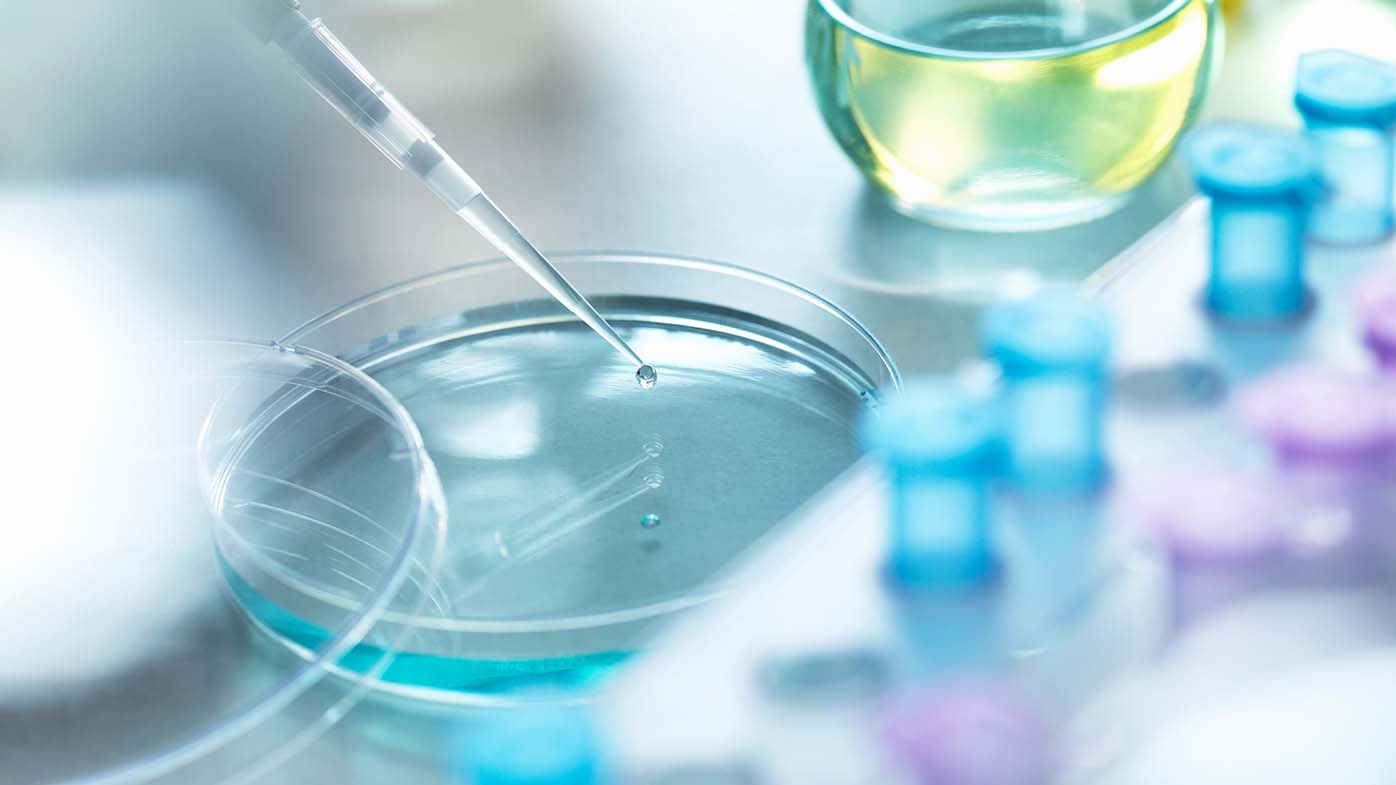

Sabine Maier, MD, Head of Oncology and Clinical Development
Initial research of immune checkpoint inhibition was a time of rapid development for the field of immuno-oncology and new research that came with a lot of unknowns. While we had our hypotheses, we didn’t know exactly what tumor types would respond to checkpoint inhibition and we didn’t initially know if they should be used alone or in combination with other treatments.
What we’ve found is that some checkpoint inhibitors can be combined to yield a stronger immune response in certain patient populations. Despite the incredible progress that has already been made, there is still so much undiscovered power in checkpoint inhibition. We have a large program researching advanced diseases, but the complexity of cancer means that we will never have a single approach that works for everyone, making it critical to have multiple options.
By leveraging new mechanisms and exploring how we can combine novel and existing treatments, we’re able to better tailor treatment options to the needs of each individual patient. We saw success by combining PD-1 and CTLA-4 inhibitors, which inspired us to explore the potential of inhibiting the LAG-3 pathway. We are also further diversifying our pipeline to include multiple different approaches to tackle remaining areas of high unmet medical need. The last decade of hard work, millions of hours of research, data and discovery has unearthed an important repository of life-changing knowledge in the field.
In addition, we’re now seeing – and leading – a second revolution in checkpoint inhibition where these therapies are being explored in earlier stages of cancers to prevent disease from returning after surgery. As we look to the future, it is my hope as an individual and our hope as a company that we can address the unmet needs that still exist for people with cancer. But this can’t be done overnight and it can’t be done alone. The advancements made in the last ten years are a testament to the great progress that is possible and we can go even further by working with healthcare providers, advocates and other leaders in the oncology community. We are working hard every day to deliver transformational science to help patients live better, healthier lives.